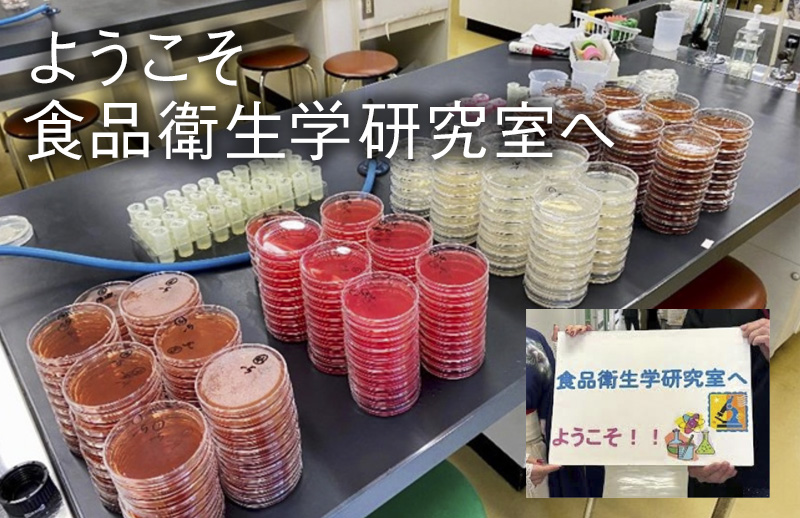

食品衛生学研究室(大道 公秀 准教授)
研究室の紹介
食品衛生とは、人類が安定的に安全な食品を入手するための状態・方法・知恵であるといえます。その食品衛生を確かなものにするための科学・技術の開発、整理、普及について研究室では取り組んでまいります。現代における各種課題について取り組むことはもちろんのこと、食品衛生の歴史、食生活と衛生との関わりについての歴史的探求や、今後懸念される課題の予測と課題解決に必要なことについても考えていきます。過去・現在・未来の視点からの食品衛生学を目指していきます。
私たち食品衛生学研究室では、食品の様々な衛生管理やカビ毒の安定性、古代食品の再現とその科学的考察を中心に取り組んでいますが、「食の健全性」という視点から、食生活と栄養に関わる幅広いテーマについての研究も取り扱っています。
学生によるコメント
私たちは個人やグループで興味のあるテーマについて調査や実験を進めています。
11月の常盤祭ではゼミ生で協力し、研究テーマにも関係する古代食の販売を行い、見事成功しました。試作を重ね食べやすいようにアレンジして販売したところ、物珍しさやおいしいと評判ですぐ売り切れ、ゼミ生とも距離が縮まったことも嬉しく印象に残っています。
私はカビ毒の安定性について、どのように分解して減少させるのか日々実験、研究を行っていました。初めて使う機械について説明を受けるところから始まり、自分に出来るか不安なことも多くありましたが、分かるまで教えて下さる大道先生と、一緒に考えてくれるゼミ生のおかげで理解が深まっています。
大道先生は、テーマを決める時も親身になって相談に乗って下さり、分からないことや今後どう実験を進めていくかも一緒に悩んで決めて下さるのでとても心強いです。先生やゼミ生揃ってマイペースなので、自分のペースで進めたい私にはとても良い環境でお菓子を食べたり談笑しながら楽しく研究に取り組めました。
研究室イベント

- 4月
- 顔合わせ&第1回目のゼミ:自己紹介や研究に対する考え方について話し合います。
- 9月
- 中間発表会:研究の進捗状況をゼミ生で確認しあって意見交換を行います。
- 11月
- 学園祭です。2025年度は模擬店を出店しました。
- 12月
- 卒業研究発表会(管理栄養士専攻の場合)です。研究成果を発表します。
- 1月
- 卒業論文の提出(管理栄養士専攻の場合)です。
- 1月以降
- 管理栄養士国家試験に向けて、研究室で自由に勉強しても良いと伝えています。ゼミ生の中には研究室で勉強している学生もいます。
- 3月
- 管理栄養士国家試験
- 3月
- 国家試験の後に、次年度4年生に向けて、引継ぎを行います。
- 3月
- 卒業式です。卒業おめでとう!活躍を祈っています!
卒業論文のテーマ(卒業論文の研究成果)
- 食品用抗菌シートの効果(この研究内容を、学生が第19回給食経営管理学会で学会発表しました)
- 古代インド及び中国の文献を参考にした醍醐再現の試みと考察(この研究内容を、学生が第33回体力・栄養・免疫学会で学会発表しました)
- モルガン菌によるヒスタミン生成に関する一考察
- 20代女性の歯周病リスクと生活習慣
- 古代のお菓子の再現と給食への応用の可能性
- 冷凍前後での鶏肉中の細菌数
- マクロファージ生存率に着目したデオキシニバレノールの毒性に関する基礎実験
- 甘酒の日焼け防止効果、皮膚状態および免疫細胞生存率の探索
- 水道水の水源になり得る河川水の水質調査・分析
- 「賞味期限切れ食品」が食品ロスに与える影響
- ワサビで処理した食品の保存性
- カードランの溶存状態
- デオキシニバレノール配糖体の安定性
など
受験生へのメッセージ
大学では興味のあることや好きなことにいっぱいチャレンジできます。大学生活を通じて自分自身の成長を楽しめるとも思います。
食生活学の研究も、そして自分とはなんなんだろうという研究も、ぜひ楽しみながら探求してみてはいかがでしょうか。







